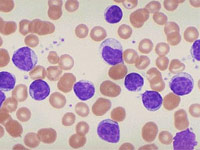

|
Científicos descubren que las células neuronales se 'resetean' para originar un tumor
 Miércoles, 30/1/2013 - 12:48
Miércoles, 30/1/2013 - 12:48
El glioblastoma es el tumor más común y maligno entre las neoplasias de la glÃa. Hasta ahora se creÃa que estos tumores surgÃan a partir de células madre neuronales no diferenciadas, capaces de transformarse en distintas células del sistema nervioso.
Leer más...
|
|
Desvelan el genoma completo del cáncer de páncreas
 Domingo, 20/1/2013 - 14:21
Domingo, 20/1/2013 - 14:21
Los investigadores descubrieron mutaciones en los genes que participan en la modificación de la cromatina (cambios que afectan a la forma del ADN en el interior de la célula) y la orientación axón (el proceso por el cual crece el axón).
Leer más...
|
|
Cuanto más obeso, menos testosterona
 Martes, 8/1/2013 - 5:43
Martes, 8/1/2013 - 5:43
Además de las consecuencias negativas sobre la reproducción, los bajos niveles de testosterona tienen aaumentar la grasa abdominal, reducir la masa muscular y desarrollar resistencia a la insulina, favoreciendo la diabetes.
Leer más...
|
|
Científicos identifican las células que originan la leucemia
 Domingo, 6/1/2013 - 20:53
Domingo, 6/1/2013 - 20:53
La investigación, publicada en la revista 'Nature Genetics' y dirigida por Carlos López-OtÃn, revela más de un millón de alteraciones epigenéticas, un hallazgo inesperado que mejorará el diagnóstico de los pacientes con este tipo de cáncer.
Leer más...
|
|
El cáncer de mama podría detectarse con un análisis de sangre
 Viernes, 28/12/2012 - 20:33
Viernes, 28/12/2012 - 20:33
Un análisis de sangre podrÃa convertirse en una técnica de diagnóstico del cáncer de mama más eficaz que las mamografÃas, según indicó este miércoles un equipo de investigadores británicos financiados por la organización benéfica Cancer Research UK.
Leer más...
|
|
Identificadas alteraciones asociadas a mal pronóstico en cáncer de colon
 Miércoles, 26/12/2012 - 17:44
Miércoles, 26/12/2012 - 17:44
CientÃficos del Centro de Investigación del Cáncer, el Hospital Universitario de Salamanca y la Universidad de Salamanca han identificado alteraciones cromosómicas en el cáncer colorrectal asociadas a un mayor riesgo de desarrollar metástasis y, por lo tanto, una progresión de la enfermedad.
Leer más...
|
|
Científicos de Estados Unidos descubren nueva enfermedad similar al sida
 Miércoles, 26/12/2012 - 15:11
Miércoles, 26/12/2012 - 15:11
Investigadores han identificado una nueva enfermedad misteriosa que ha causado sÃntomas similares al sida en decenas de personas en Asia y algunas en Estados Unidos, aun cuando no están infectados con VIH.
Leer más...
|
|
Descubren una nueva ruta en la metástasis del cáncer de mama
 Martes, 25/12/2012 - 17:51
Martes, 25/12/2012 - 17:51
El grupo de investigación liderado por el doctor Xose Bustelo, investigador principal del Centro de Investigación del Cáncer de Salamanca y profesor de investigación del CSIC, ha descubierto una nueva vÃa de señalización que condiciona el crecimiento de tumores de mama y su diseminación metastática hacia el pulmón.
Leer más...
|
|
Descubren que las bacterias intestinales influyen en la aparición de la diabetes
 Martes, 25/12/2012 - 11:49
Martes, 25/12/2012 - 11:49
Investigadores han descubierto que la composición de las bacterias intestinales podrÃa influÃr en el desarrollo de la enfermedad. Las personas que la padecen tienen una composición de bacterias más hostil, por lo que aumenta su resistencia a los medicamentos.
Leer más...
|
|
Cáncer de mama y ovario, más cerca de lo que se creía
 Lunes, 24/12/2012 - 10:56
Lunes, 24/12/2012 - 10:56
Algunos tumores de mama están genéticamente más cerca del cáncer de ovario, que de otras variedades de cáncer de mama. Un amplio análisis publicado en el último número de la revista 'Nature' ha permitido identificar algunas de las caracterÃsticas comunes de ambas enfermedades, lo que a la larga podrÃa repercutir en las opciones de tratamiento.
Leer más...
|
|
Científicos españoles descubren elementos comunes entre anorexia y obesidad
 Jueves, 20/12/2012 - 13:39
Jueves, 20/12/2012 - 13:39
Investigadores españoles han demostrado que grupos en condiciones extremas de peso, como anorexia nerviosa y obesidad, pueden compartir factores de riesgo biológico y fenotipos neurocognitivos.
Leer más...
|
|
Científicos españoles identifican 78 genes implicados en leucemia linfática
Jueves, 20/12/2012 - 8:57
Jueves, 20/12/2012 - 8:57
Un equipo de investigadores españoles ha identificado 78 nuevos genes implicados en la leucemia linfática crónica -la más frecuente-, alguno de los cuales permite anticipar la evolución de esta enfermedad.
Leer más...
|
|
Investigadores de Tel Aviv y Afula descubren la causa del síndrome SOFT
 Lunes, 17/12/2012 - 18:27
Lunes, 17/12/2012 - 18:27
Un equipo de investigadores israelÃes de los centros médicos Sourasky, de Tel Aviv, y Emek, de Afula, descubrió una mutación genética que vincula la piel y los huesos y provoca una rara enfermedad conocida como el 'sÃndrome SOFT'.
Leer más...
|
|
Científicos de Salamanca descubren que el mieloma múltiple se organiza como un tejido
 Viernes, 14/12/2012 - 11:8
Viernes, 14/12/2012 - 11:8
Este descubrimiento explica un hecho que se sabe hace mucho tiempo: que aunque la mayor parte de los pacientes con mieloma múltiple responden a la terapia, tan sólo una minorÃa son curados. Ahora, el desafÃo pasa por encontrar la manera de destruir las células.
Leer más...
|
|
|







